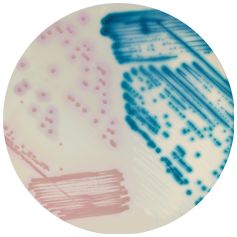
CHROMagar™ LIN-R - 5000 ml

MR502
For the isolation and differentiation of Methicillin Resistant Staphylococcus aureus (MRSA) including low level MRSA
Package size: 5000 ml
DKK 2.250,00
DKK 3.000,00
Not in stock, delivery 1-2 weeks
CHROMagar ™ LIN-R is a qualitative chromogenic screening medium for the detection, isolation and differentiation of strains of Staphylococcus and Enterococcus resistant to linezolid.
The product is composed of a powder base (B) and a supplement (S).
MEDIUM PERFORMANCE:
1. High Sensitive: Detection of MIC as low as 8 µg/mL.
2. Directly from specimen
3. Easy identification: Species identification by MALDI-TOF can be carried directly from a colony.
4. With experience, a trained eye can differentiate between E. faecium and E. faecalis, and between S. aureus and S. epidermidis.
TYPICAL APPEARANCE OF MICROORGANISMS:
LZD-R Staphylococcus → pink
LZD-R Enterococcus → steel blue
Gram (+) cocci pose a global threat to human health due to the emergence of resistance to antibiotics.
Linezolid has a broad spectrum of activity against a variety o f pathogenic Gram ( +) microorganisms, such as MRSA, VRS, and VRE. However, the emergence of strains resistant to linezolid (LIN-R) and horizontal spread of resistance linked to the cfr gene, have been increasingly reported after approval of its clinical use. Although the prevalence of linezolid resistance remains low, the emergence of LIN-R strains is still a great concern.
Today, linezolid sensitivity in Gram (+) clinical specimens is primarily monitored by surveillance programs in Europe and in the United States. Clinical isolates for surveillance of LIN-R strains include swabs from the nose (for screening of Staphylococcus), perianal and rectal areas (for screening of Enterococcus).